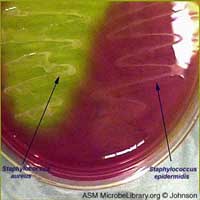
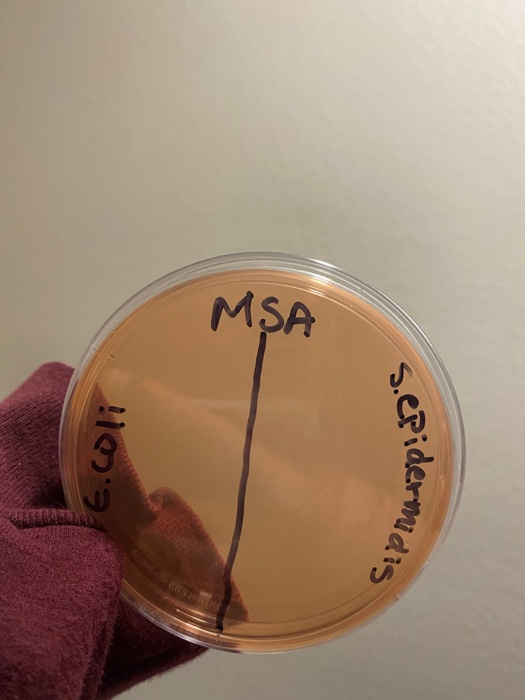

Msa Plate

Msa Plate

Mannitol Salt Agar Msa Usp For Staphylococcus 15x100mm Plate Har

Staphylococcus Aureus And Staphylococcus Epidermidis On Mannitol Salt Agar Mannitol Salt Agar Composition Positive And Negative Result On Mannitol Salt Agar

Bacterial Colonies Streak Plate Free Images Photographs Page 2

Mannitol Salt Agar Msa Plate

Mannitol Salt Agar Petri Dish Msa Isolated On White Background Stock Photo Image Of Assay Medicine


Welcome To Microbugz Mannitol Salt Agar

Mannitol Salt Agar Msa For Staphylococcus

Mannitol Salt Agar Msa Usp For Staphylococcus 15x100mm Plate Har

Selective And Differential Media Ppt Video Online Download

Solved Question 1 This Is A Mannitol Salt Msa Plate Wh Chegg Com

Solved After Observing The Results From Your Blood Agar P Chegg Com

Micro Lab Exam 4 Flashcards Quizlet

Microbiology Lab Molb 2210

Laboratory Methods For Identification Of Bacteria Ppt Video Online Download

Mannitol Salt Agar Msa Bacterial Growth Medium Microbiology Lab Tutorial Youtube

Mannitol Salt Agar Msa Mycrobe

Mannitol Salt Agar Plate Test Composition Preparation Uses Laboratoryinfo Com

Mannitol Salt Bacterial Growth Medium Msa Page 2

Solved Steps X Paste Layor Reler Male Revie View Help Ta Chegg Com

Asmscience Mannitol Salt Agar Plates Protocols

Culture Media Microbiology Resource Center Truckee Meadows Community College

Mannitol Salt Agar Microbiology Images Photographs From Science Prof Online

Msa D Plate Anchorage Connector Zinc Plated Steel Saferite Solutions Inc

Name Date Mannitol Salt Agar Plate Msa Your Result Chegg Com

Mannitol Salt Agar For The Isolation Of Staphylococcus Aureus

Solved Help With The Following Regarding Mantiol Salt Aga Chegg Com

Mannitol Salt Agar Msa Test Scientist Cindy

Mannitol Salt Bacterial Growth Medium Msa

Msa Sightgard Shade 5 Heat Treated Polycarbonate Welding Plate 2 Amazon Com Industrial Scientific

Any Idea What This Could Be Msa Plate Contaminated With Something Honestly Asking Just Out Of Purely Out Of Curiosity Microbiology

Msa Rope Termination Plate

A Growth Of Isolated Strain On Msa Plate And B Growth Of Isolated Download Scientific Diagram
3

Mannitol Salt Agar Microbiology Images Photographs From Science Prof Online
_(1).jpg?bwg=1562148427)
Micr350 Streaked Images

I Ve Attached Lab Worksheets And Images Phenylet Chegg Com

Solved 25 Bacteria Have Been Inoculated On This Mannitol Chegg Com

Msa Suretyman Termination Plate For 5 8 Rope Mfg Sriw1000 Durawear Com

Isolation And Identification Of Staphylococci Staphylococci Microbiology Of The Respiratory Tract

Gram Positive Sphere Unknown Msa Mannitol Salt Agar Plate Flashcards Quizlet

Msa Zinc Plated Steel D Plate Anchorage Connector Amazon Com Industrial Scientific
.jpg)
Welcome To Adobe Golive 4

Solved Microbiology Question In Lab I Was Given Three U Chegg Com
Summers Bio315

Mannitol Salt Agar Msa Composition Uses And Colony Characteristics Learn Microbiology Online

Mannitol Salt Agar Wikipedia
1

Antimicrobial Drug List Microbiology Medical Laboratory Science Medical Laboratory

Mannitol Salt Agar Msa Composition Uses And Colony Characteristics Learn Microbiology Online
_(1).jpg?bwg=1562148427)
Micr350 Streaked Images

Welcome To Adobe Golive 4

Photo 40 1 Staphylococcus Aureus Cultured On Mannitol Salt Agar Msa Download Scientific Diagram

Microbiology Lab Molb 2210

Solved Below Are The Results For Two Different Differenti Chegg Com

Virtual Lab 3 tc

The Belly Button Can Act As A Reservoir For Staphylococcus Aureus Cleaning The Area With Chlorhexidine Can Reduce And Possibly Eliminate Its Presence Staphacne

Types Of Culture Media Pptx 2

Tina Torres Bacillus Thuringiensis Microbewiki
Msa Plate S Aureus Drone Fest

Solved Mannitol Salt Agar Msa What Makes This Plate Se Chegg Com
Solved 5 What Is A Mannitol Salt Agar Msa Normally Use Chegg Com

Sagitha Agar Plate

Mannitol Salt Agar Plate Test Composition Preparation Uses Laboratoryinfo Com

Microbiology Lab 7 Flashcards Easy Notecards

Product Catalog

Lab Photos Riley Lab

Mannitol Salt Plate Or Msa Youtube

Mannitol Salt Agar

Asmscience Mannitol Salt Agar Plates Protocols

Experiment 8c Lab08 Virtual Edge Molb 21 College Of Agriculture And Natural Sciences

Ex 14 Skin Cultures And Importance Of Selective And Differential Media For Isolating Gram Positive Cocci Objectives Ppt Download

Culture Media Microbiology Resource Center Truckee Meadows Community College

Microbiology 2125 Occc Hovda Lab Final Flashcards Memorang

Mannitol Salt Agar Test Msa Flashcards Quizlet

Hardy Diagnostics Mannitol Salt Agar Msa Usp For Staphylococcus 15x100mm Plate Order By The Package Of 10 Science Lab Agar Media Amazon Com Industrial Scientific

Microbio 225 Lab Test 3 Selective And Differential Media Imvic Biochem Tests With Some Bacterial Samples Flashcards Questions And Answers Quizlet

Experiment 8c Lab08 Virtual Edge Molb 21 College Of Agriculture And Natural Sciences

Mannitol Salt Agar Msa Plate

Welcome To Adobe Golive 4

Ilovemicrobiology Ilana Kovach

Mannitol Salt Agar Msa Images Stock Photos Vectors Shutterstock

Mannitol Salt Agar Msa Test Scientist Cindy

Mannitol Salt Agar Msa Composition Uses And Colony Characteristics Learn Microbiology Online

Mannitol Salt Agar Microbiology Images Photographs From Science Prof Online

Summary Of Bi 101j Gen Bio Unseen Life On Earth Su Stearns

15x100mm Plate Msa Order By The Package Of 10 Hardy Diagnostics Mannitol Salt Agar Usp For Staphylococcus Industrial Scientific Lab Scientific Products
Q Tbn 3aand9gcs3nlev0tx1pfsddwm6y9ajujk4lxjzmg7ksdxctgnipv0l50c Usqp Cau

When The Professor Says You Can Swab Anything For Your Msa Plate Microbiology

Pin On Medical Laboratory And Biomedical Science

Mannitol Salt Agar Msa Test Scientist Cindy

Selective And Diff Media List
Q Tbn 3aand9gcq0fb7kqcd3bewi3vuqqhupwlp4bqj Qjkilrelsirym2lkqaox Usqp Cau

N6zgcskp8osg2m

Media Used For Bacterial Growth Microbiology

Mannitol Salt Agar Microbiology Images Photographs From Science Prof Online

Mannitol Salt Agar Plate Test Composition Preparation Uses Laboratoryinfo Com
Nanopdf Com Download Ex 13 Selective Media For Isolating Gram Pdf

Tsa 5 Emb Msa Mycobiotic Culture Quad Plate 10 Pk Henry Schein Medical

Mannitol Salt Bacterial Growth Medium Msa Page 2

Mannitol Salt Agar Msa Results Theory Youtube

Mannitol Salt Agar Msa Test Superfarmer S Weblog

Figure 1 From Detection Of Panton Valentine Leukocidin Pvl Genes Within Ca Mrsa Carriers Of The Oral Roberts University Community Semantic Scholar

Msa 5 8 Inch Termination Plate



